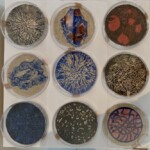

Benoît Saison, artiste visuel de Calais, a bénéficié de la « carte blanche » 2024 à la galerie Caléidoscopes. Nous nous souvenons tous de la magie de ses installations « hors cadre » en janvier – février 2024.
En 2025, Benoît Saison est associé aux artistes génois Luisa Rognoni Apedistri et Fulvio Ioan pour une nouvelle carte blanche qui rebondira en février – mars 2025 à Gênes.
Partager :
- Cliquez pour partager sur Facebook(ouvre dans une nouvelle fenêtre) Facebook
- Cliquez pour partager sur Threads(ouvre dans une nouvelle fenêtre) Threads
- Cliquer pour partager sur Mastodon(ouvre dans une nouvelle fenêtre) Mastodon
- Cliquer pour partager sur Bluesky(ouvre dans une nouvelle fenêtre) Bluesky
- Cliquez pour partager sur LinkedIn(ouvre dans une nouvelle fenêtre) LinkedIn
- Cliquer pour envoyer un lien par e-mail à un ami(ouvre dans une nouvelle fenêtre) E-mail